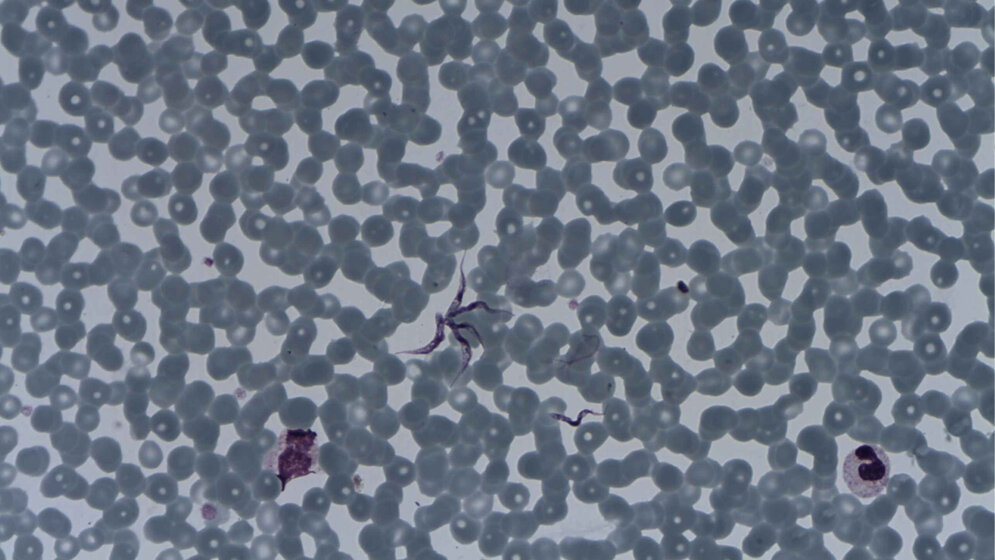
Trypanosoma brucei

Afrikanische Trypanosomen, die Erreger der Schlafkrankheit, sind berüchtigt für ihre Fähigkeit, der körpereigenen Immunabwehr zu entkommen. Der Trick, mit dem sie sich der vollständigen Vernichtung durch die Abwehrzellen entziehen, ist bereits seit Jahrzehnten bekannt.
Bedeckt mit VSGs
Die einzelligen Parasiten sind von einer dichten Schicht identischer Proteine bedeckt, den so genannten VSGs (variable surface glycoproteins). Gegen diese Proteine richten sich Antiköper des infizierten Menschen, und die Parasiten werden dadurch großenteils eliminiert. Doch gelegentlich wechseln einzelne Erreger ihr Oberflächenprotein komplett aus. Dazu schalten sie einfach auf ein anderes VSG-Gen um – sie haben an die tausend verschiedene davon zur Verfügung.
„Das ist, als würden sie einen neuen Mantel anziehen“, sagt Nina Papavasiliou, Immunologin im Deutschen Krebsforschungszentrum (DKFZ). Die so maskierten Trypanosomen werden von den Antikörpern nicht mehr erkannt, vermehren sich rasend, und die Infektion, die das Immunsystem zunächst in Schach gehalten hatte, flammt wieder heftig auf.
Zuckermoleküle spielen auch eine Rolle
„Wir sind jahrzehntelang davon ausgegangen, dass nur die veränderten Aminosäurebausteine der neuen VSGs dafür verantwortlich sind, dass die Erreger dem Immunsystem entkommen“, sagt Erec Stebbins, ebenfalls am DKFZ. „Doch jetzt haben wir entdeckt, dass auch Zuckermoleküle eine Rolle dabei spielen und es dem körpereigenen Immunsystem noch schwerer machen, mit dem Parasiten fertig zu werden.“
Stebbins und sein Team haben nun verschiedene VSGs per Röntgenstrukturanalyse untersucht. Bei einem der Moleküle, VSG3, entdeckten die Forscher auf der dem Immunsystem zugewandten „Außenseite“ Bindestellen für Zuckermoleküle. Mit weiteren Untersuchungen stellte Michael Ferguson von der Universität Dundee, Schottland, fest, dass diese Bindestellen auch tatsächlich mit einer Vielzahl verschiedener Zucker besetzt sind.
Zuckerketten behindern Immunabwehr
Um herauszufinden, ob die Zuckerketten Einfluss auf die Vermehrung der Parasiten bzw. auf den Erfolg der Immunabwehr haben, schufen die Wissenschaftler um Papavasiliou mit molekularbiologischen Methoden Trypanosomen, deren VSG3 die Zuckerbindestelle fehlte. Während Mäuse, die mit normalen Trypanosomen infiziert wurden, schnell an der Infektion starben, überlebten die Tiere eine Infektion mit „zuckerfreien“ Trypanosomen und konnten den Erreger nach einigen Tagen gänzlich aus ihrem Blut eliminieren.
Geimpft mit zuckerfreien, abgetöteten Trypanosomen entwickelten Mäuse eine schützende Immunantwort. Die Übertragung von Erregern mit normalem, zuckerhaltigem VSG löste dagegen keinen Impfschutz aus. Die Bindestellen für den Zucker fanden die Forscher nicht nur am VSG3, sondern auch bei zahlreichen anderen VSGs.
„Die Zuckerketten des VSG legen die Immunabwehr nicht komplett lahm. Aber sie behindern sie eindeutig. Neben dem Umschalten auf neue VSGs sind die verschiedenartigen Zucker eine zusätzliche Strategie, mit der die Parasiten es dem Immunsystem schwer machen, den Erreger zu eliminieren“, erklärt Papavasiliou.
Zuckermoleküle sind wichtige Erkennungsstrukturen
Wie genau die Zucker das Abwehrsystem behindern, können die Forscher derzeit noch nicht sagen. „Möglicherweise verdecken sie teilweise die Bindestellen der Antikörper“, mutmaßt Stebbins und weist darauf hin, dass veränderte Zuckermoleküle auch die Immunabwehr von Krebszellen beeinflussen können: „Zuckermoleküle sind sehr wichtige Erkennungsstrukturen für das Immunsystem. Das gilt für die Abwehr von Mikroorganismen ebenso wie für die Immunabwehr von Tumoren.“
Trypanosoma brucei, der Erreger der afrikanischen Schlafkrankheit, tritt vor allem in West- und Zentralafrika auf. Der durch die Tsetse-Fliege übertragene Erreger greift das zentrale Nervensystem an und verursacht schwere neurologische Störungen. Ohne Behandlung kann die Infektion zum Tod führen. Die Zahl der gemeldeten Fälle ging zuletzt zurück, sie sank zwischen 1999 und 2015 um 90 Prozent, von 28.000 auf 2.800 Patienten (Quelle: Medecins sans Frontieres, DKFZ).
Jason Pinger, Dragana Nešić, Liaqat Ali, et al.: African trypanosomes evade immune clearance by O-glycosylation of the VSG surface coat. Nature Microbiology 2018, DOI: 10.1038/s41564-018-0187.
Artikel teilen